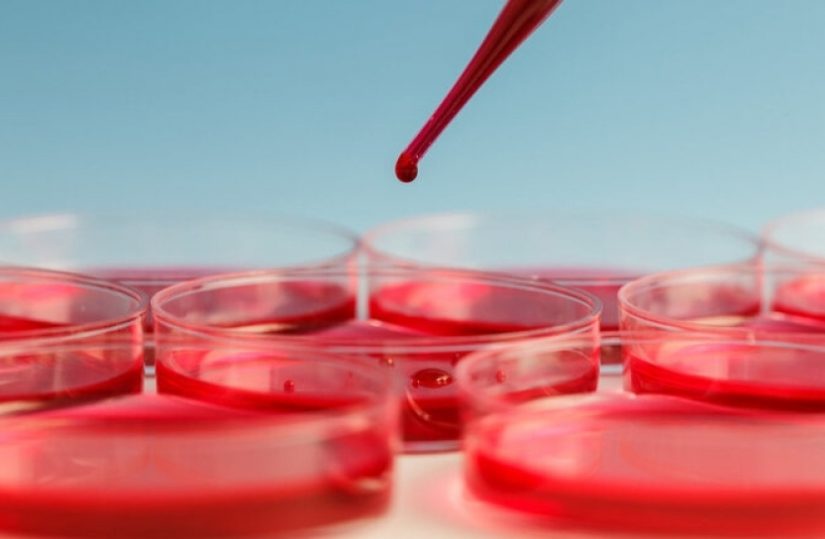

15 Out 2021
Dor Neuropática do Doente Oncológico e Sobrevivente de Cancro: Qual o impacto desta pandemia?
As principais causas de Dor Neuropática Periférica Localizada (DNPL) no doente oncológico e sobrevivente de cancro são a própria doença...15 Out 2021
Dor Neuropática relacionada com o cancro: um problema exacerbado pela situação de pandemia
A prática clínica teve obrigatoriamente de se alterar, tal como o modo de relacionamento entre médico e doente e entre...15 Out 2021
Reforço de profissionais no SNS
Relativamente às demissões de profissionais de saúde de diferentes hospitais do País, a governante indicou que desde dezembro de 2020...15 Out 2021
Tiago Maricoto: 7.as Jornadas do GRESP querem “colocar os cuidados de saúde respiratórios na agenda das prioridades das unidades de CSP”
Jornal Médico (JM) | Como antecipa que será este reencontro presencial entre colegas passado todo este tempo de confinamento? Tiago...14 Out 2021
Aspirina para prevenir primeiro enfarte ou AVC apenas em casos de risco
“Só num grupo restrito de pessoas com muito risco (...) pode ser benéfico fazer aspirina antes de qualquer evento cardiovascular”,...14 Out 2021
Pesquisas na Internet podem ajudar a prever hospitalizações por asma
O estudo, já publicado no Journal of Medical Internet Research, refere que esta possibilidade “poderá permitir uma adequada preparação hospitalar...13 Out 2021
Utentes têm perceção favorável sobre medicamentos genéricos
Três quartos da população inquirida equiparam os medicamentos genéricos aos medicamentos originadores em termos de qualidade, eficácia, segurança e regulação/controlo...13 Out 2021
Carlos Rabaçal: “A MGF faz parte do grupo que tem a aterosclerose como um inimigo comum”
Jornal Médico (JM) | Estamos na XXIX edição do Congresso Português de Aterosclerose. Quais os saltos qualitativos da história deste...12 Out 2021
APDI debate futuro da Doença Inflamatória do Intestino
Segundo a presidente da APDI, Ana Sampaio, a sociedade passa por tempos conturbados e as pessoas com doença de Crohn...12 Out 2021
Saúde com mais 703 milhões de euros face a 2021
“O Programa Orçamental da Saúde evidencia, no OE de 2022, uma dotação de despesa total consolidada de 13.578,1 milhões de...11 Out 2021
Trombose: GESCAT alerta para perigo da doença
“Silenciosa, assintomática, repentina e grave. A trombose é uma doença causada pela formação de um coágulo sanguíneo numa veia, principalmente...11 Out 2021
APDP organiza mesa-redonda sobre cancro da próstata
No evento vão existir dois painéis de debate: “Cancro da Próstata e a realidade nacional: Necessidades e desafios” e “Tornar...11 Out 2021
Combate à discriminação de utentes LGBT+ a diferentes velocidades
“O médico deve prestar a sua atividade profissional sem qualquer forma de discriminação” (Artigo 4º do Código Deontológico da Ordem...08 Out 2021
Pandemia: estudo calcula mais de 25% de casos de depressão e ansiedade
O estudo, já publicado na revista científica The Lancet, recolheu dados em 204 países e territórios, concluindo que a pandemia...08 Out 2021
Projeto de exercício físico para doentes com leucemia e linfomas
“Mais Momento Mais Vida”. É este o nome da iniciativa desenvolvida de forma “a que os doentes e familiares possam...08 Out 2021